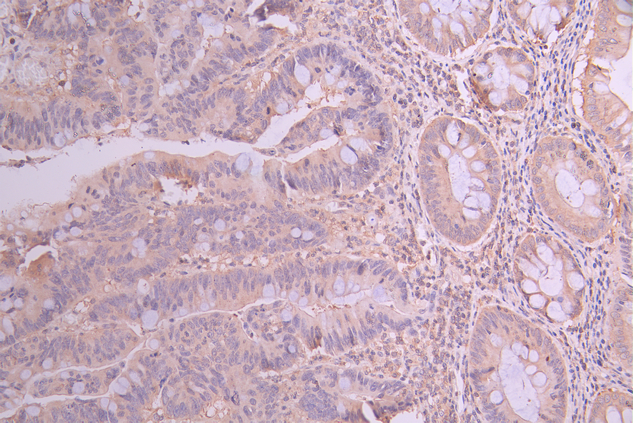

-
中文名稱:TPM1 Recombinant Monoclonal Antibody
-
貨號:CSB-RA295233A0HU
-
規格:¥1320
-
圖片:
-
IHC image of CSB-RA295233A0HU diluted at 1:100 and staining in paraffin-embedded human colorectal cancer performed on a Leica BondTM system. After dewaxing and hydration, antigen retrieval was mediated by high pressure in a citrate buffer (pH 6.0). Section was blocked with 10% normal goat serum 30min at RT. Then primary antibody (1% BSA) was incubated at 4°C overnight. The primary is detected by a Goat anti-rabbit polymer IgG labeled by HRP and visualized using 0.05% DAB.
-
Overlay Peak curve showing 786-O cells stained with CSB-RA295233A0HU (red line) at 1:100. The cells were fixed in 4% formaldehyde and permeated by 0.2% TritonX-100 for 10min. Then 10% normal goat serum to block non-specific protein-protein interactions followed by the antibody (1ug/1*106cells) for 45min at 4℃. The secondary antibody used was FITC-conjugated goat anti-rabbit IgG (H+L) at 1/200 dilution for 35min at 4℃.Control antibody (green line) was Rabbit IgG (1ug/1*106cells) used under the same conditions. Acquisition of >10,000 events was performed.
-
-
其他:
產品詳情
-
Uniprot No.:
-
基因名:
-
別名:AA986836 antibody; AI854628 antibody; Alpha tropomyosin antibody; alpha-TM antibody; Alpha-tropomyosin antibody; C15orf13 antibody; cardiomyopathy; hypertrophic 3 antibody; CMD1Y antibody; CMH3 antibody; HTM alpha antibody; HTM-alpha antibody; OTTHUMP00000163688 antibody; sarcomeric tropomyosin kappa antibody; TM2 antibody; Tmpa antibody; TMSA antibody; Tpm-1 antibody; TPM1 antibody; TPM1_HUMAN antibody; tropomyosin 1 (alpha) antibody; tropomyosin 1 (alpha) isoform 1 antibody; tropomyosin 1 (alpha) isoform 2 antibody; tropomyosin 1 (alpha) isoform 3 antibody; tropomyosin 1 (alpha) isoform 4 antibody; tropomyosin 1 (alpha) isoform 5 antibody; tropomyosin 1 (alpha) isoform 6 antibody; tropomyosin 1 (alpha) isoform 7 antibody; Tropomyosin 1 antibody; Tropomyosin alpha 1 chain antibody; Tropomyosin alpha-1 chain antibody; Tropomyosin; skeletal muscle alpha antibody; Tropomyosin-1 antibody
-
反應種屬:Human
-
免疫原:A synthesized peptide derived from human TPM1
-
免疫原種屬:Homo sapiens (Human)
-
標記方式:Non-conjugated
-
克隆類型:Monoclonal
-
抗體亞型:Rabbit IgG
-
純化方式:Affinity-chromatography
-
克隆號:6H8
-
濃度:It differs from different batches. Please contact us to confirm it.
-
保存緩沖液:Rabbit IgG in 10mM phosphate buffered saline , pH 7.4, 150mM sodium chloride, 0.05% BSA, 0.02% sodium azide and 50% glycerol.
-
產品提供形式:Liquid
-
應用范圍:ELISA, IHC, FC
-
推薦稀釋比:
Application Recommended Dilution IHC 1:50-1:200 FC 1:50-1:200 -
Protocols:
-
儲存條件:Upon receipt, store at -20°C or -80°C. Avoid repeated freeze.
-
貨期:Basically, we can dispatch the products out in 1-3 working days after receiving your orders. Delivery time maybe differs from different purchasing way or location, please kindly consult your local distributors for specific delivery time.
-
用途:For Research Use Only. Not for use in diagnostic or therapeutic procedures.
相關產品
靶點詳情
-
功能:Binds to actin filaments in muscle and non-muscle cells. Plays a central role, in association with the troponin complex, in the calcium dependent regulation of vertebrate striated muscle contraction. Smooth muscle contraction is regulated by interaction with caldesmon. In non-muscle cells is implicated in stabilizing cytoskeleton actin filaments.
-
基因功能參考文獻:
- Missense variant (p.Leu113Val) in TPM1 causes left ventricular non-compaction with Ebstein anomaly in five members of the family. PMID: 29024827
- miR-107 overexpression promoted U2OS cell viability, migration, and invasion via downregulation of TPM1 and might be through activating the MEK/ERK and NF-kappaB signaling pathways. PMID: 28276320
- Functional effects of substitutions I92T and V95A in actin-binding period 3 of tropomyosin. PMID: 29496559
- This study demonstrated that sarcomeric TPM1 plays vital roles in cardiogenesis and is a suitable candidate gene for screening individuals with isolated congenital heart defects . PMID: 28359939
- Tpm isoforms 1.8/9 are enriched in the lamellipodium of fibroblasts as detected with a novel isoform-specific monoclonal antibody. RNAi-mediated silencing of Tpm1.8/9 led to an increase of Arp2/3 accumulation at the cell periphery and a decrease in the persistence of lamellipodia and cell motility. PMID: 27112294
- TPM1-AS regulates the alternative splicing of TPM1 through an interaction with RBM4 and involves in TPM1-mediated filopodium formation and migration of cancer cells PMID: 28754317
- The impact of tropomyosins on actin filament assembly is isoform specific. PMID: 27420374
- TPM1 is the second gene linked to EA with LVNC in humans, implicating overlap in the molecular basis of structural and myopathic heart disease. PMID: 27177193
- Stress fibre formation and up-regulation of alpha-smooth muscle actin (alphaSMA) induced by TGFbeta2 could be reversed by Tpm1/2 knock-down by siRNA. PMID: 27976512
- data demonstrate that the K15N mutation alters pointed end dynamics by affecting molecular interactions between Tpm1.1, Lmod2 and Tmod1. PMID: 28732641
- Results report evidence for the existence of variants in LHFPL2 and TPM1 with low allele frequencies and large effects on age-at-onset of familial Parkinson's disease. PMID: 27402877
- In diabetes, expression of high molecular weight (HMW) isoforms from tropomyosin 1 (TPM1) were markedly decreased but HMW isoforms from tropomyosin 4 (TPM4) were not significantly different. PMID: 27649540
- results suggest that TPM1 can suppress tumors in oral squamous cell carcinoma, and the TPM1 expression level is related to oral squamous cell carcinoma patient prognosis PMID: 28182650
- Data indicate that various hypertrophic cardiomyopathy (HCM) mutations can differently affect the structural and functional properties of tropomyosin (Tpm) and cause HCM by different molecular mechanisms. PMID: 27983818
- Promoter variants in HOXA9, TPM1, and TPM2, alter promoter expression suggesting that they have a functional role in clubfoot. PMID: 27020427
- The TPM1 mutations D175N and E180G increased the sliding velocity and its calcium sensitivity of the actin-myosin Interaction, while mutation E40K reduced both these parameters. PMID: 27878731
- No association was observed between the remaining three markers (rs11071720, rs3803499, and rs12148828) and NSOC as well as its subgroups. TPM1 polymorphisms might contribute to the etiology ofnonsyndromic orofacial clefts (NSOC), , and more emphasis should be placed on TPM1 during craniofacial development PMID: 26792422
- We propose that TR100 acts to compromise the integrity of Tpm cables rather than prevent overlap complex formation. Our data suggests that TR100 is incorporated into the growing actin-Tpm co-polymer given that its effects cannot be observed on pre-formed Tpm3.1/actin filaments PMID: 26804624
- Structural stabilization of F-actin, by overexpression of tropomyosin-1, preserves cell to cell interactions through the attenuation of cortical actin organization into thin fibers and thus protects these cells against oxidative stress-induced degradation of actin cytoskeleton and cell death. PMID: 26805581
- This is the first report of an association between Familial hypertrophic cardiomyopathy (HCM) and Brugada Syndrome (BrS), and the first to use a combined approach of linkage and NGS to identify a causative mutation in SD. The present study expands the clinical spectrum of disorders associated with theTPM1gene and may be useful to report novel mechanisms of electrical instability in HCM and BrS. PMID: 26960954
- Data confirm that the substitutions of the Tpm1 residues G126 and D137 with the canonical ones, Arg and Leu, respectively, increase the stiffness of the Tpm coiled-coil PMID: 26200873
- these results indicate that TPM1 may be one mechanism underlying radiation resistance, and TPM1 may be a potential target for overcoming the radiation resistance in glioma. PMID: 25873252
- Mitochondrial RNA induces tropomyosin synthesis. PMID: 25408381
- TPM1 exhibits characteristics of a tumor-suppressor gene while being overexpressed in Renal cell carcinoma cell lines. PMID: 25607530
- We have quantified the expression of the total sarcomeric TPM1 and observed a 1.5-fold increase in treated cells. PMID: 24958154
- Coexistence of Digenic Mutations in Both TPM1 and MYH7 Genes Leads to Severe Hypertrophic Cardiomyopathy. PMID: 25607779
- Mutant TPM1cause m ultiple functional alterations in actin affinity and Ca2+ sensitivity. PMID: 25548289
- cardiomyopathy-associated E62Q tropomyosin mutation weakens actin-tropomyosin interaction, but phosphorylation of neighboring S61 rescues the binding-deficit, results confirmed experimentally by in vitro motility assays. PMID: 25241052
- effects of the mutations in the TPM1 gene on hypertrophic cardiomyopathy and dilated cardiomyopathy development (Review) PMID: 24005378
- Vardenafil administration improved erectile functionality in controlled type 2 diabetes mellitus patients with ED, which was associated with reduction of circulating plasma beta-tropomyosin levels. PMID: 24112450
- In addition to CLIC1 and TPM1, which were the proteins initially discovered in a xenograft mouse model, CLIC4, TPM2, TPM3, and TPM4 were present in ovarian cancer patient sera at significantly elevated levels compared with controls. PMID: 23792823
- These data indicated that TPM1 is downregulated in HuCCT1 cells and that the Ras signaling pathway as well as DNA methylation, histone deacetylation and miR-21 upregulation play important roles in the suppression of TPM1 expression in HuCCT1 cells. PMID: 23254774
- Elevated TPM1 and TPM2 expression is associated with epithelial-mesenchymal transition of lens epithelial cells. PMID: 23205574
- TPM1-D175N and myosin-binding protein-Q1061X mutations account for a substantial part of all hypertrophic cardiomyopathy (HCM) cases in the Finnish population. Routine genetic screening of these mutations is warranted in Finnish patients with HCM. PMID: 22462493
- A novel TPM-1 mutation associates with dilated and non-compaction cardiomyopathy and diminishes actin binding. PMID: 23147248
- analysis of the pattern of of evolutionarily conserved basic and acidic residues that constitutes the binding interface of actin-tropomyosin PMID: 23420843
- Expression of low molecular weight isoforms from TPM1 and TPM3 genes is regulated very differently, which has a critical role in processes such as cancer metastasis. PMID: 22740512
- Persistence length of human cardiac alpha-tropomyosin measured by single molecule direct probe microscopy PMID: 22737252
- Familial hypertrophic cardiomyopathy mutation E180G enhances Ca(2+)-sensitivity in functional assays. Increased flexibility of the mutant was confirmed by fitting end-to-end length distributions to the worm-like chain model. PMID: 22958892
- Downregulation of tropomyosin-1 in squamous cell carcinoma of esophagus. PMID: 22965424
- Patients with HCM attributable to D175N mutation of alpha-tropomyosin were studied by CMRI. LV maximal thickness by CMRI is the best parameter in differentiating between LVH due to mild-to-moderate hypertension and HCM attributable to a sarcomeric mutation. PMID: 21274714
- this study compared the bending flexibility of wild-type tropomyosin to that of two mutant tropomyosins, Asp175Asn and Glu180Gly, known to be associated with hypertrophic cardiomyopathy. PMID: 22789852
- variable myocardial and systemic inflammatory response was demonstrated in patients with HCM attributable to an identified sarcometric mutation. PMID: 22447464
- Functional and structural differences in three familial hypertrophic cardiomyopathy-related mutations in recombinant alpha-Tm were characterized using both conventional and modified in vitro motility assays and circular dichroism spectroscopy. PMID: 22187526
- This work studied how the hypertrophic cardiomyopathy-causing Asp175Asn and Glu180Gly mutations in alpha-tropomyosin affect on actin-myosin interaction during the ATPase cycle PMID: 22155441
- identified 5 mutations in cardiac myosin-binding protein C (MYBPC3) and 2 mutations in alpha-tropomyosin (TPM1) in a cohort of unrelated adult probands with isolated left ventricular noncompaction cardiomyopathy PMID: 21551322
- This is the first report of mutations in TPM1, MY L3, and MYL2 associated with primary, non-hypertrophied restrictive cardiomyopathy. PMID: 21823217
- IgE recognition profile of profilins, PR-10 proteins and tropomyosin, were evaluated. PMID: 21949785
- effect of Glu40Lys mutant alpha-tropomyosin on the mobility and rotation of subdomain-1 of actin and the SH1 helix of myosin subfragment-1 during the ATP hydrolysis cycle has been demonstrated PMID: 21741356
- TPM1 is a potential candidate disease-causing gene for isolated LVNC, especially in patients experiencing sudden death. PMID: 20965760
顯示更多
收起更多
-
相關疾病:Cardiomyopathy, familial hypertrophic 3 (CMH3); Cardiomyopathy, dilated 1Y (CMD1Y); Left ventricular non-compaction 9 (LVNC9)
-
亞細胞定位:Cytoplasm, cytoskeleton.
-
蛋白家族:Tropomyosin family
-
組織特異性:Detected in primary breast cancer tissues but undetectable in normal breast tissues in Sudanese patients. Isoform 1 is expressed in adult and fetal skeletal muscle and cardiac tissues, with higher expression levels in the cardiac tissues. Isoform 10 is ex
-
數據庫鏈接:
Most popular with customers
-
-
YWHAB Recombinant Monoclonal Antibody
Applications: ELISA, WB, IHC, IF, FC
Species Reactivity: Human, Mouse, Rat
-
Phospho-YAP1 (S127) Recombinant Monoclonal Antibody
Applications: ELISA, WB, IHC
Species Reactivity: Human
-
-
-
-
-